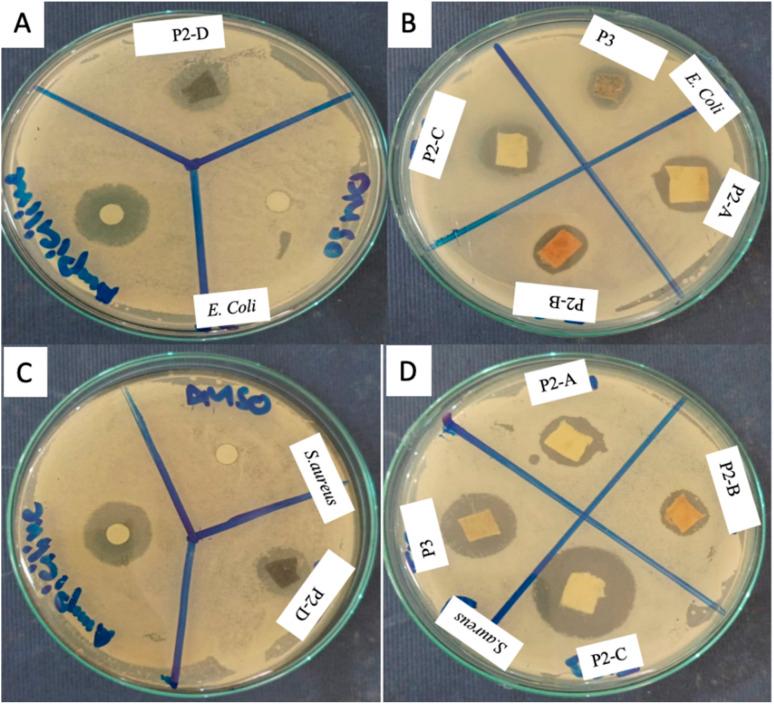
https://cdn.ncbi.nlm.nih.gov/pmc/blobs/ac3f/11104733/de1c02550c5c/d4ra00724g-f11.jpg

基于还原氧化石墨烯的金属纳米复合材料改性的高效芳纶纤维支撑聚丙烯膜:抗菌和抗病毒能力
Highly efficient aramid fiber supported polypropylene membranes modified with reduced graphene oxide based metallic nanocomposites: antimicrobial and antiviral capabilities.
作者信息
Mustafa Kiran, Iqbal Nadeem, Ahmad Sajjad, Iqbal Sadia, Rezakazemi Mashallah, Verpoort Francis, Kanwal Javaria, Musaddiq Sara
机构信息
Department of Chemistry, The Women University Multan 66000 Pakistan
Govt. Graduate College (W), Higher Education Department Khanewal Punjab Pakistan.
出版信息
RSC Adv. 2024 May 20;14(23):16421-16431. doi: 10.1039/d4ra00724g. eCollection 2024 May 15.
Polypropylene hybrid polymeric membranes with aramid support have been fabricated using Thermally Induced Phase Separation (TIPS). Different modifying materials, such as metallic nanoparticles and reduced graphene oxide (rGO), improve the properties of these membranes. The nanomaterials and the fabricated membranes have been characterized with FTIR spectrometer, SEM and UV-Vis Spectrophotometer. Following that, the disinfection capabilities of the fabricated hybrid membranes were investigated. The antibacterial capability of the membranes is established through the testing of the membranes against bacterial strains and , whereas the antiviral evaluation of the membranes was made against and strains. This research aims to develop advanced hybrid membranes that effectively disinfect water by incorporating novel nanomaterials and optimizing fabrication techniques.
采用热致相分离(TIPS)法制备了具有芳纶支撑的聚丙烯杂化聚合物膜。不同的改性材料,如金属纳米颗粒和还原氧化石墨烯(rGO),改善了这些膜的性能。利用傅里叶变换红外光谱仪、扫描电子显微镜和紫外可见分光光度计对纳米材料和制备的膜进行了表征。在此之后,研究了制备的杂化膜的消毒能力。通过对膜针对细菌菌株 和 进行测试来确定膜的抗菌能力,而针对 和 菌株对膜进行了抗病毒评估。本研究旨在通过结合新型纳米材料和优化制备技术来开发能有效对水进行消毒的先进杂化膜。